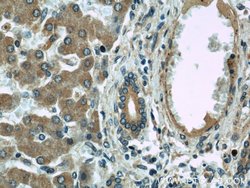
SAR1B Rabbit anti-Human, Mouse, Rat, Polyclonal, Proteintech 150 &mu;L;

missing translation for 'onlineSavingsMsg'
Learn More
Learn More
SAR1B Rabbit anti-Human, Mouse, Rat, Polyclonal, Proteintech
Rabbit Polyclonal Antibody
Brand: Proteintech 22292-1-AP-150UL
This item is not returnable.
View return policy
Description
The antibody is specific to SAR1B.
The protein encoded by this gene is a small GTPase that acts as a homodimer. The encoded protein is activated by the guanine nucleotide exchange factor PREB and is involved in protein transport from the endoplasmic reticulum to the Golgi. This protein is part of the COPII coat complex. Defects in this gene are a cause of chylomicron retention disease (CMRD), also known as Anderson disease (ANDD). Two transcript variants encoding the same protein have been found for this gene.Specifications
| SAR1B | |
| Polyclonal | |
| Unconjugated | |
| SAR1B | |
| ANDD, CMRD, GTBPB, GTP binding protein B, GTP binding protein SAR1b, SAR1 homolog B (S. cerevisiae), SAR1B, SARA2, SARB | |
| Rabbit | |
| Antigen Affinity Chromatography | |
| RUO | |
| 287276, 51128, 66397 | |
| -20°C | |
| Liquid |
| Immunohistochemistry (Paraffin), Western Blot | |
| 0.3 mg/mL | |
| PBS with 50% glycerol and 0.02% sodium azide; pH 7.3 | |
| Q5HZY2, Q9CQC9, Q9Y6B6 | |
| Sar1b | |
| Peptide | |
| 150 μL | |
| Primary | |
| Human, Mouse, Rat | |
| Antibody | |
| IgG |
Product Content Correction
Your input is important to us. Please complete this form to provide feedback related to the content on this product.
Product Title
Spot an opportunity for improvement?Share a Content Correction